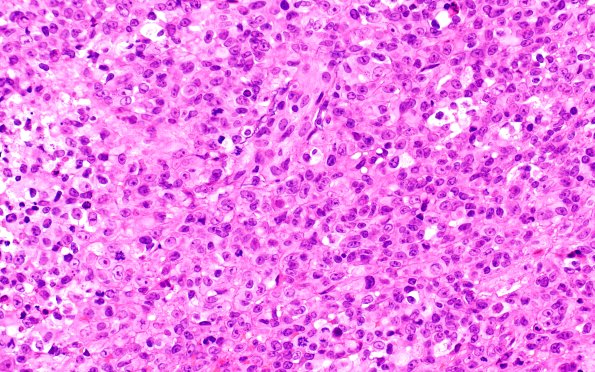
20B4 ATRT (NP24-888) A2 H&E 40X 1

Table of Contents
Washington University Experience | NEOPLASMS (EMBRYONAL) | ATRT - Atypical Teratoid Rhabdoid Tumor | 20B4 ATRT (NP24-888) A2 H&E 40X 1
The majority of tumor cells have a rhabdoid appearance with large eccentric nuclei and prominent nucleoli with abundant eosinophilic cytoplasm, while a subset of cells have a more spindled appearance. Mitoses are brisk and there are scattered areas of tumor necrosis noted. Additionally, there are areas with a suggestion of a myxoid matrix and a more chordoid appearance. (H&E)